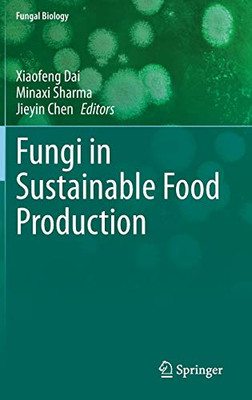
Fungi In Sustainable Food Production (Fungal Biology)

Sale
Fungi In Sustainable Food Production (Fungal Biology)
Springer
ISBN13:
9783030644055
$190.78
$170.64
- | Author: Xiaofeng Dai, Minaxi Sharma, Jieyin Chen
- | Publisher: Springer
- | Publication Date: May 30, 2021
- | Number of Pages: 246 pages
- | Language: English
- | Binding: Hardcover
- | ISBN-10: 3030644057
- | ISBN-13: 9783030644055
- Author:
- Xiaofeng Dai, Minaxi Sharma, Jieyin Chen
- Publisher:
- Springer
- Publication Date:
- May 30, 2021
- Number of pages:
- 246 pages
- Language:
- English
- Binding:
- Hardcover
- ISBN-10:
- 3030644057
- ISBN-13:
- 9783030644055